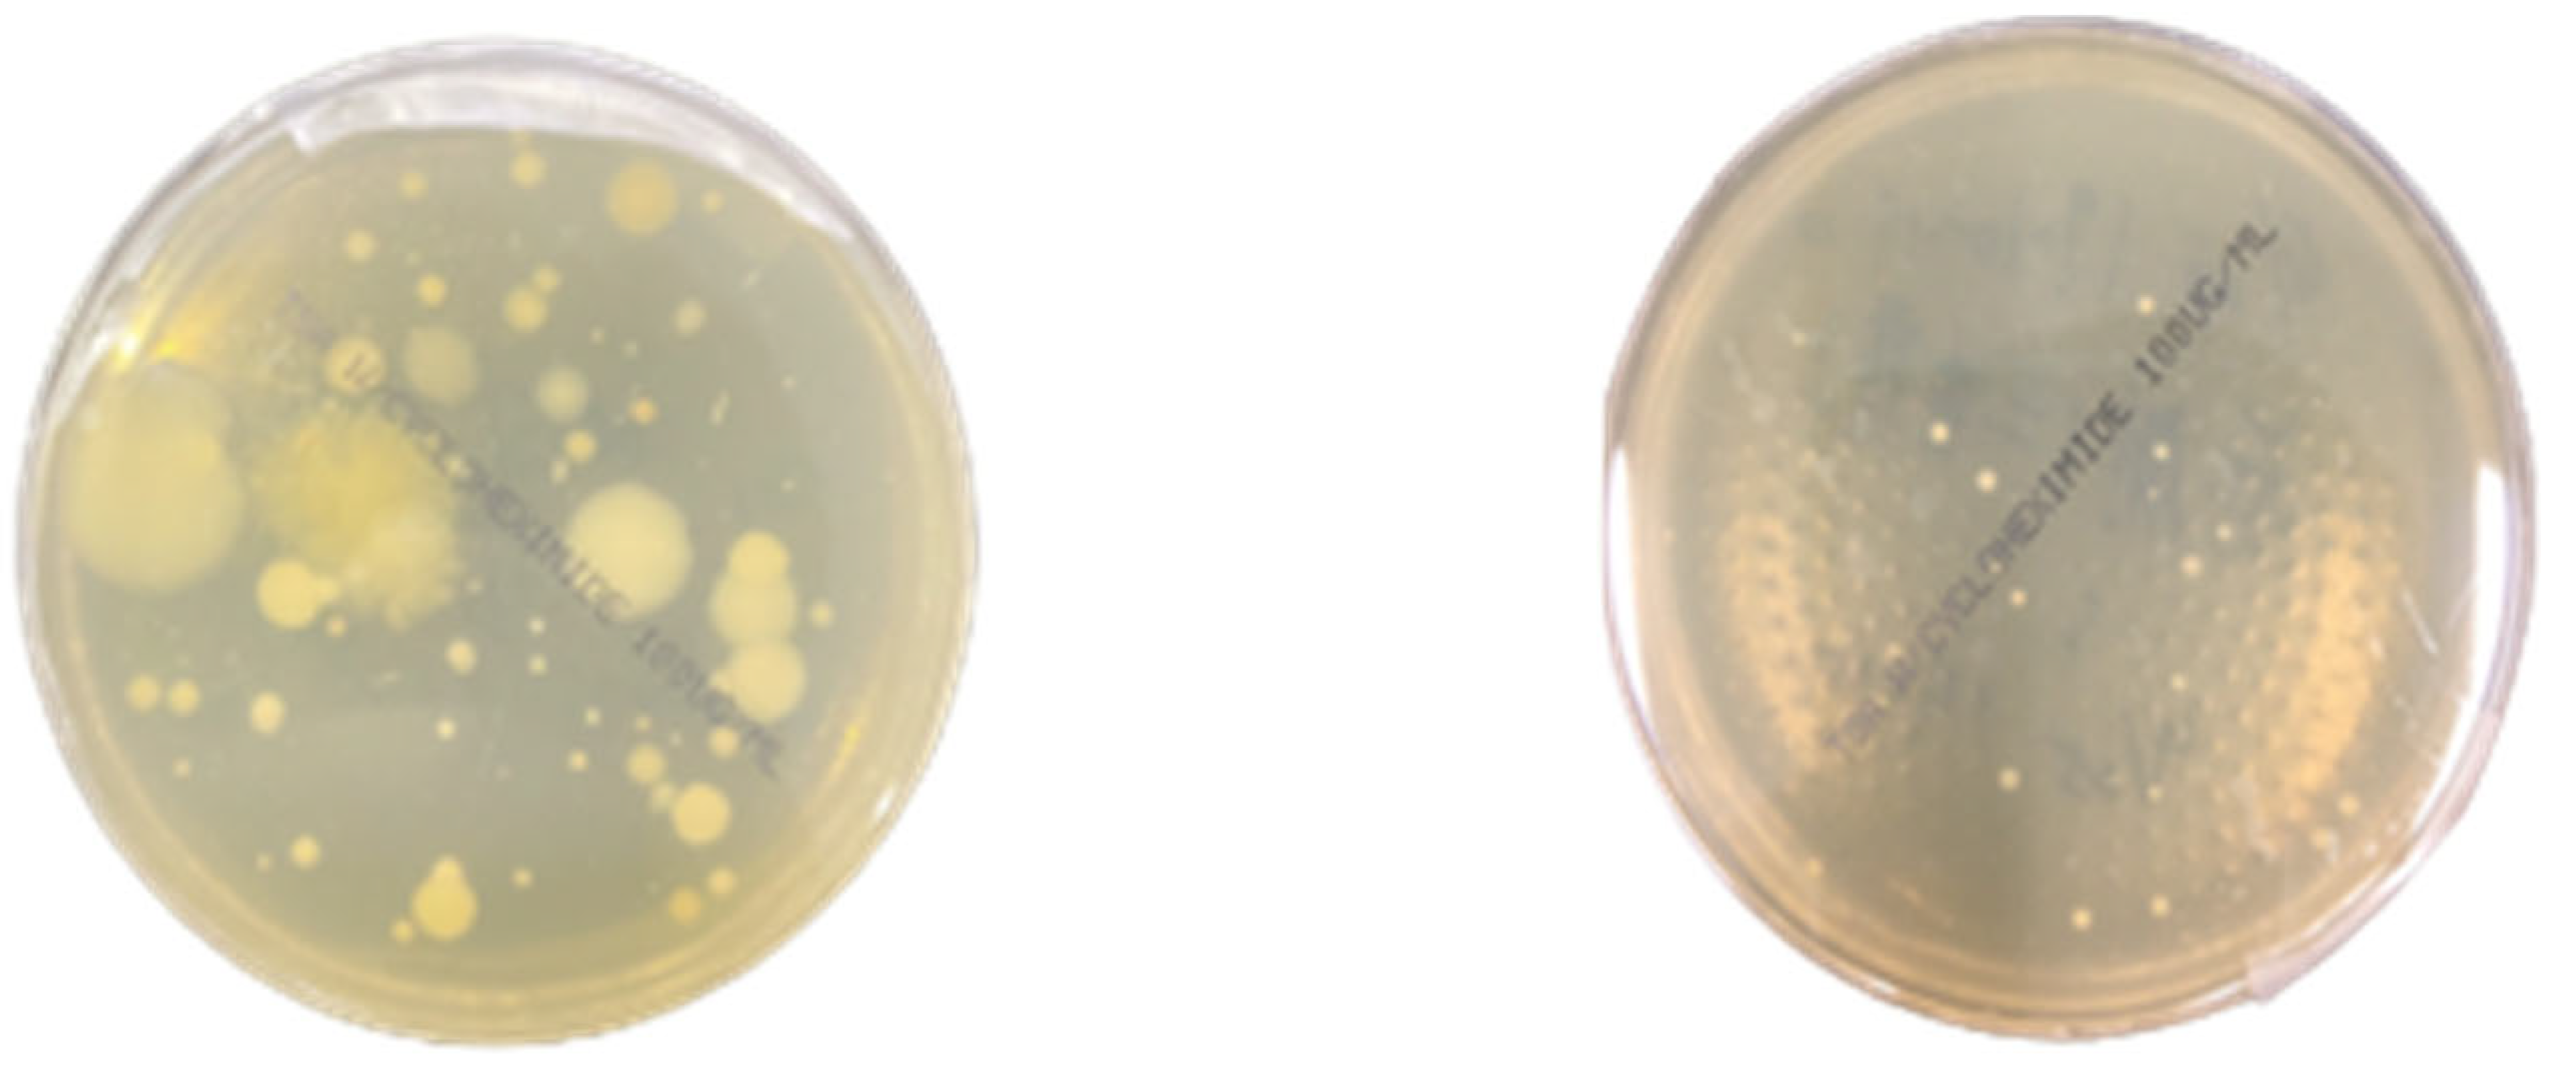
Buildings 15 01893 g005

The Validation and Performance Analysis of a UV Air-Cleaning System for the Indoor Air Quality of Populated Indoor Spaces
Abstract
1. Introduction
2. Materials and Methods
2.1. Experimental Area
2.2. Energy Recovery System (Energy Recovery Ventilator)
2.3. Air Boxes for Indoor Air Quality Monitoring
2.4. Single-Stage Viable Impactor Sampling System
2.5. Investigating the Bacterial Concentrations in the Air
2.6. The Design of UV Air-Cleaning Device
2.7. Performance Testing
2.8. K-M Model
3. Results
3.1. Results with ERV Turned on Only
3.1.1. Sampling of CO2 and Airborne Particle Concentrations
3.1.2. CO2 and PM2.5 Concentrations
3.2. Results with Both ERV and UV
The CFU Reduction Performance
4. Discussion
Application of K-M Model
5. Conclusions
Author Contributions
Funding
Data Availability Statement
Conflicts of Interest
References
- Petrović, N.; Kocić, Ð. IoT for COVID-19 Indoor Spread Prevention: Cough Detection, Air Quality Control and Contact Tracing. In Proceedings of the 2021 IEEE 32nd International Conference on Microelectronics (MIEL), Nis, Serbia, 12–14 September 2021; pp. 297–300. [Google Scholar]
- Sung, W.-T.; Hsiao, S.-J. Building an indoor air quality monitoring system based on the architecture of the Internet of Things. EURASIP J. Wirel. Commun. Netw. 2021, 2021, 153. [Google Scholar] [CrossRef]
- Hudson, J.; Sharma, M.; Vimalanathan, S. Development of a Practical Method for Using Ozone Gas as a Virus Decontaminating Agent. Ozone Sci. Eng. 2009, 31, 216–223. [Google Scholar] [CrossRef]
- ANSI/ASHARE Standard 62.1; Ventilation and Acceptable Indoor Air Quality. ASHRAE: Washington, DC, USA, 2022; ISSN 1041-2336.
- Casini, B.; Tuvo, B.; Cristina, M.L.; Spagnolo, A.M.; Totaro, M.; Baggiani, A.; Privitera, G.P. Evaluation of an Ultraviolet C (UVC) Light-Emitting Device for Disinfection of High Touch Surfaces in Hospital Critical Areas. Int. J. Environ. Res. Public Health 2019, 16, 3572. [Google Scholar] [CrossRef] [PubMed]
- Kim, S.-H.; Chang, S.Y.; Sung, M.; Park, J.H.; Kim, H.B.; Lee, H.; Choi, J.-P.; Choi, W.S.; Min, J.-Y. Extensive Viable Middle East Respiratory Syndrome (MERS) Coronavirus Contamination in Air and Surrounding Environment in MERS Isolation Wards. Clin. Infect. Dis. 2016, 63, 363–369. [Google Scholar] [CrossRef] [PubMed]
- Shen, J.; Kong, M.; Dong, B.; Birnkrant, M.J.; Zhang, J. A systematic approach to estimating the effectiveness of multi-scale IAQ strategies for reducing the risk of airborne infection of SARS-CoV-2. Build. Environ. 2021, 200, 107926. [Google Scholar] [CrossRef] [PubMed]
- Nardell, E.A. Air Disinfection for Airborne Infection Control with a Focus on COVID-19: Why Germicidal UV is Essential†. Photochem. Photobiol. 2021, 97, 493–497. [Google Scholar] [CrossRef] [PubMed]
- Gardner, A.; Ghosh, S.; Dunowska, M.; Brightwell, G. Virucidal Efficacy of Blue LED and Far-UVC Light Disinfection against Feline Infectious Peritonitis Virus as a Model for SARS-CoV-2. Viruses 2021, 13, 1436. [Google Scholar] [CrossRef] [PubMed]
- Heilingloh, C.S.; Aufderhorst, U.W.; Schipper, L.; Dittmer, U.; Witzke, O.; Yang, D.; Zheng, X.; Sutter, K.; Trilling, M.; Alt, M.; et al. Susceptibility of SARS-CoV-2 to UV irradiation. Am. J. Infect. Control 2020, 48, 1273–1275. [Google Scholar] [CrossRef] [PubMed]
- Liang, J.-J.; Liao, C.-C.; Chang, C.-S.; Lee, C.-Y.; Chen, S.-Y.; Huang, S.-B.; Yeh, Y.-F.; Singh, K.J.; Kuo, H.-C.; Lin, Y.-L.; et al. The Effectiveness of Far-Ultraviolet (UVC) Light Prototype Devices with Different Wavelengths on Disinfecting SARS-CoV-2. Appl. Sci. 2021, 11, 10661. [Google Scholar] [CrossRef]
- Memarzadeh, F.; Xu, W. Role of air changes per hour (ACH) in possible transmission of airborne infections. Build. Simul. 2012, 5, 15–28. [Google Scholar] [CrossRef] [PubMed]
- Lelieveld, J.; Helleis, F.; Borrmann, S.; Cheng, Y.; Drewnick, F.; Haug, G.; Klimach, T.; Sciare, J.; Su, H.; Pöschl, U. Model Calculations of Aerosol Transmission and Infection Risk of COVID-19 in Indoor Environments. Int. J. Environ. Res. Public Health 2020, 17, 8114. [Google Scholar] [CrossRef] [PubMed]
- Buchan, A.G.; Yang, L.; Atkinson, K.D. Predicting airborne coronavirus inactivation by far-UVC in populated rooms using a high-fidelity coupled radiation-CFD model. Sci. Rep. 2020, 10, 19659. [Google Scholar] [CrossRef] [PubMed]
- Ciugudeanu, C.; Beu, D.; Buzdugan, M. SteriLightVent—Hybrid UV Lighting Decontamination Device. In Proceedings of the 2021 International Conference on Applied and Theoretical Electricity (ICATE), Craiova, Romania, 27–29 May 2021; pp. 1–5. [Google Scholar]
- Trivellin, N.; Buffolo, M.; Onelia, F.; Pizzolato, A.; Barbato, M.; Orlandi, V.T.; Del Vecchio, C.; Dughiero, F.; Zanoni, E.; Meneghesso, G.; et al. Inactivating SARS-CoV-2 Using 275 nm UV-C LEDs through a Spherical Irradiation Box: Design, Characterization and Validation. Materials 2021, 14, 2315. [Google Scholar] [CrossRef] [PubMed]
- Jensen, P.A. Critical Design Parameters in Design and Efficacy of Upper-Room UVC254 Luminaire Systems: Part I: Overview of Major Parameters and Relationships. Photochem. Photobiol. 2021, 97, 532–541. [Google Scholar] [CrossRef] [PubMed]
- Kahn, K.; Mariita, R.M. Quantifying the Impact of Ultraviolet Subtype C in Reducing Airborne Pathogen Transmission and Improving Energy Efficiency in Healthy Buildings: A Kahn–Mariita Equivalent Ventilation Model. Front. Built Environ. 2021, 7, 121. [Google Scholar] [CrossRef]
- MAPSV6-User Manual. Available online: https://maps6-user-guide.gitbook.io/maps6-manual-book-en (accessed on 23 December 2024).
- Hsu, L.-H. The Application of Flow Field Simulation and the Detachable Germicidal Air Unit to the Improvement of Indoor Air Quality. Master’s Thesis, National Taiwan University, Taipei, Taiwan, 2023; pp. 1–88. [Google Scholar]
- EN HOME Sankyo-Denki. Available online: https://www.sankyo-denki.co.jp/en-uv-c-lamps (accessed on 23 December 2024).

| Condition index | 1 | 2 | 3 | 4 | 5 | 6 | 7 | 8 | 9 | 10 | 11 | 12 |
| Fan air speed | L | L | L | L | M | M | M | M | H | H | H | H |
| Group index | 2 | 2 | 4 | 4 | 2 | 2 | 4 | 4 | 2 | 2 | 4 | 4 |
| Reduction time | 30 | 60 | 30 | 60 | 30 | 60 | 30 | 60 | 30 | 60 | 30 | 60 |
| Two-Group UV Lamps | Four-Group UV Lamps | ||||||
|---|---|---|---|---|---|---|---|
| Location | Fan Coil Air Velocity (m/s) | Background Value Concentration (CFU/m3) | 30 min Concentration (CFU/m3) | 60 min Concentration (CFU/m3) | Background Value Concentration (CFU/m3) | 30 min Concentration (CFU/m3) | 60 min Concentration (CFU/m3) |
| FCU | 1.0 | 473.5 | 130.8 | 63.6 | 265 | 77.8 | 60.1 |
| 1.6 | 473.5 | 74.2 | 60.1 | 473.5 | 130.7 | 70.7 | |
| 2.2 | 346.3 | 56.6 | 31.9 | 88.4 | 74.2 | 67.2 | |
| experimental area | 1.0 | 381.7 | 99.0 | 53.0 | 540.7 | 99.0 | 53.0 |
| 1.6 | 466.5 | 176.7 | 141.4 | 466.5 | 236.8 | 159.0 | |
| 2.2 | 416.9 | 250.9 | 127.2 | 328.6 | 144.9 | 120.1 | |
| office area | 1.0 | 402.9 | 88.3 | 38.9 | 378.2 | 88.3 | 56.6 |
| 1.6 | 607.8 | 222.6 | 229.7 | 607.8 | 215.6 | 148.4 | |
| 2.2 | 445.2 | 176.6 | 162.6 | 282.7 | 95.4 | 77.7 | |
| Two-Group UV Lamps | Four-Group UV Lamps | ||||
|---|---|---|---|---|---|
| Location | Fan Coil Air Velocity (m/s) | 30 min CFU Reduction Rates (%) | 60 min CFU Reduction Rates (%) | 30 min CFU Reduction Rates (%) | 60 min CFU Reduction Rates (%) |
| FCU | 1.0 | 72.4 | 86.6 | 70.7 | 77.3 |
| 1.6 | 84.3 | 87.3 | 72.4 | 85.1 | |
| 2.2 | 83.7 | 90.8 | 16.0 | 24.0 | |
| experimental area | 1.0 | 74.1 | 86.1 | 81.7 | 90.2 |
| 1.6 | 62.1 | 69.7 | 49.2 | 65.9 | |
| 2.2 | 39.8 | 69.5 | 55.9 | 63.5 | |
| office area | 1.0 | 78.1 | 90.4 | 76.7 | 85.1 |
| 1.6 | 63.4 | 62.2 | 64.5 | 75.6 | |
| 2.2 | 60.3 | 63.5 | 66.3 | 72.5 | |
| Reduction Rate | ||||
|---|---|---|---|---|
| Group Index | Reduction Time | L | M | H |
| 2 | 30 | 72.4% | 84.3% | 83.7% |
| 2 | 60 | 86.6% | 87.3% | 90.8% |
| 4 | 30 | 70.7% | 72.4% | 16.0% |
| 4 | 60 | 77.3% | 85.1% | 24.0% |
| Condition Index | CADRERV (CFM) | CADRUV (CFM) | CADRERV+UV (CFM) |
|---|---|---|---|
| 1 | 294.3 | 298.2 | 592.5 |
| 2 | 294.3 | 356.7 | 651.0 |
| 3 | 294.3 | 291.1 | 585.4 |
| 4 | 294.3 | 318.6 | 612.9 |
| 5 | 294.3 | 556.0 | 850.3 |
| 6 | 294.3 | 575.6 | 869.9 |
| 7 | 294.3 | 477.2 | 771.5 |
| 8 | 294.3 | 560.8 | 855.1 |
| 9 | 294.3 | 758.4 | 1052.7 |
| 10 | 294.3 | 823.0 | 1117.3 |
| 11 | 294.3 | 145.2 | 439.5 |
| 12 | 294.3 | 217.5 | 511.8 |
| Condition Index | CSSERV (CFU/m3) | CSSUV (CFU/m3) | CSSERV+UV (CFU/m3) |
| 1 | 69.8 | 68.9 | 34.7 |
| 2 | 69.8 | 57.6 | 316 |
| 3 | 39.08 | 39.5 | 19.7 |
| 4 | 39.08 | 36.1 | 18.8 |
| 5 | 69.8 | 37.9 | 24.2 |
| 6 | 69.8 | 35.7 | 23.6 |
| 7 | 69.8 | 43.1 | 26.6 |
| 8 | 69.8 | 36.6 | 24.0 |
| 9 | 51.1 | 19.8 | 14.3 |
| 10 | 51.1 | 18.3 | 13.4 |
| 11 | 13.0 | 26.4 | 8.7 |
| 12 | 13.0 | 17.6 | 7.5 |
| Condition Index | D90 (min) |
|---|---|
| ERV only | 25.3–49.6 |
| 1 | 22.3 |
| 2 | 19.1 |
| 3 | 22.7 |
| 4 | 21.1 |
| 5 | 12.0 |
| 6 | 11.5 |
| 7 | 14.3 |
| 8 | 11.9 |
| 9 | 8.0 |
| 10 | 7.1 |
| 11 | 35.6 |
| 12 | 28.1 |
Disclaimer/Publisher’s Note: The statements, opinions and data contained in all publications are solely those of the individual author(s) and contributor(s) and not of MDPI and/or the editor(s). MDPI and/or the editor(s) disclaim responsibility for any injury to people or property resulting from any ideas, methods, instructions or products referred to in the content. |
© 2025 by the authors. Licensee MDPI, Basel, Switzerland. This article is an open access article distributed under the terms and conditions of the Creative Commons Attribution (CC BY) license (https://creativecommons.org/licenses/by/4.0/).
Share and Cite
Chou, H.-Y.; Cheng, H.-J.; Hsu, L.-H.; Huang, C.-K. The Validation and Performance Analysis of a UV Air-Cleaning System for the Indoor Air Quality of Populated Indoor Spaces. Buildings 2025, 15, 1893. https://doi.org/10.3390/buildings15111893
Chou H-Y, Cheng H-J, Hsu L-H, Huang C-K. The Validation and Performance Analysis of a UV Air-Cleaning System for the Indoor Air Quality of Populated Indoor Spaces. Buildings. 2025; 15(11):1893. https://doi.org/10.3390/buildings15111893
Chicago/Turabian StyleChou, Hao-Yuan, Hsiu-Ju Cheng, Ling-Hang Hsu, and Chen-Kang Huang. 2025. "The Validation and Performance Analysis of a UV Air-Cleaning System for the Indoor Air Quality of Populated Indoor Spaces" Buildings 15, no. 11: 1893. https://doi.org/10.3390/buildings15111893
APA StyleChou, H.-Y., Cheng, H.-J., Hsu, L.-H., & Huang, C.-K. (2025). The Validation and Performance Analysis of a UV Air-Cleaning System for the Indoor Air Quality of Populated Indoor Spaces. Buildings, 15(11), 1893. https://doi.org/10.3390/buildings15111893








